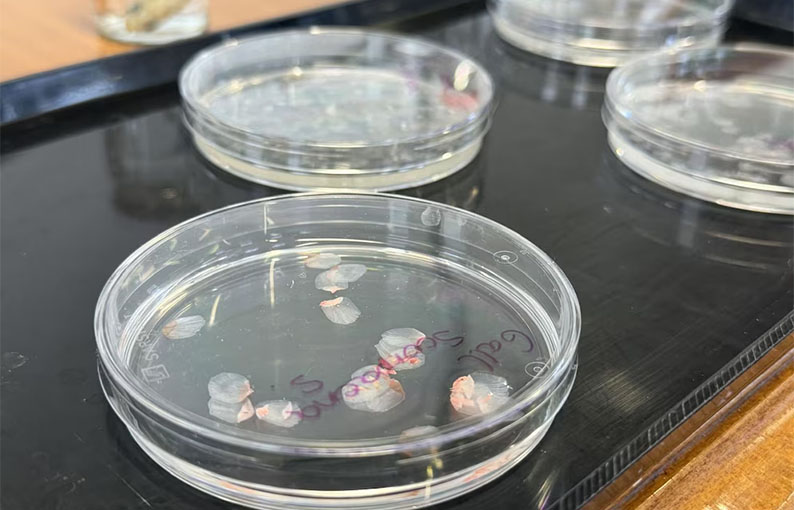

El avance científico logrado en laboratorios españoles abre nuevas posibilidades para pacientes con enfermedades visuales graves y plantea un futuro donde la escasez de donantes deje de ser una barrera para recuperar la visión
Investigadores de la Universidad de Granada desarrollaron, en sus laboratorios, implantes corneales biocompatibles a partir de escamas de pescado, con resultados positivos en pruebas de laboratorio y en animales. El avance busca ayudar a personas con enfermedades corneales graves, que enfrentan largas listas de espera por la escasez de donantes. El material, basado en escamas de carpas y peces de consumo habitual, ofrece resistencia, transparencia y bajo coste.
Según el portal de noticias Euronews, las pruebas iniciales muestran que el biomaterial cumple con los requisitos funcionales y ópticos necesarios para la reparación corneal. De acuerdo con la revista Materials & Design, el estudio liderado por el profesor universitario en Histología, Miguel Alaminos confirmó que la córnea artificial derivada de escamas resulta resistente, transparente y segura en modelos animales. Los investigadores destacaron la accesibilidad y bajo coste del material, que reutiliza un subproducto de la industria pesquera muchas veces desechado.
Además, el proyecto podría beneficiar al sector pesquero, afectado por restricciones y dificultades económicas. Según la investigadora Ingrid Garzón, transformar residuos en implantes médicos abre una vía de aprovechamiento sostenible y genera valor añadido en zonas pesqueras.
Material innovador y ventajas económicas
El uso de escamas de pescado como fuente para crear córneas artificiales se presenta como una alternativa económicamente viable frente a los trasplantes convencionales. Las escamas son fáciles de obtener y su procesamiento permite fabricar implantes de bajo coste, lo que podría reducir significativamente el precio de los procedimientos y ampliar el acceso a la cirugía ocular.
El proyecto cuenta con financiación del Instituto de Salud Carlos III, dentro del Ministerio de Ciencia, Innovación y Universidades, y despertó el interés clínico en hospitales andaluces. La presencia de representantes del Hospital Clínico San Cecilio de Granada en la presentación del estudio refleja la expectativa en el entorno médico por este avance.
Resultados y próximos pasos en la investigación
Aunque los resultados actuales se limitan a pruebas de laboratorio y experimentación animal, los datos obtenidos justifican la continuación de la investigación. El equipo de Granada demostró que el biomaterial funciona a nivel biológico y estructural, sentando las bases para futuros ensayos clínicos en humanos. De acuerdo con los responsables, el proceso para llegar a la práctica clínica requerirá cumplimiento normativo y años de validación antes de que los implantes lleguen a los quirófanos.

El hallazgo representa una esperanza en un contexto donde la escasez de donantes sigue siendo un desafío global. La posibilidad de fabricar córneas a partir de residuos pesqueros podría transformar el panorama de los trasplantes y reducir las listas de espera en oftalmología.
Impacto potencial en la salud y la industria
La creación de implantes corneales biocompatibles a partir de escamas de peces no solo mejora las perspectivas para quienes necesitan un trasplante, sino que también promueve la economía circular. Aprovechar residuos de la industria alimentaria para crear productos de alto valor médico contribuye a la sostenibilidad y al desarrollo regional.
La investigación liderada en Granada refleja la capacidad de la ciencia española para innovar y aportar soluciones a problemas médicos complejos. Si los próximos ensayos confirman la eficacia en humanos, los implantes de córnea hechos de escamas de peces podrían convertirse en una alternativa real para miles de pacientes en todo el mundo, marcando un hito en la medicina regenerativa y la gestión de recursos.
Por Ismael Yasnikowski (Infobae)











